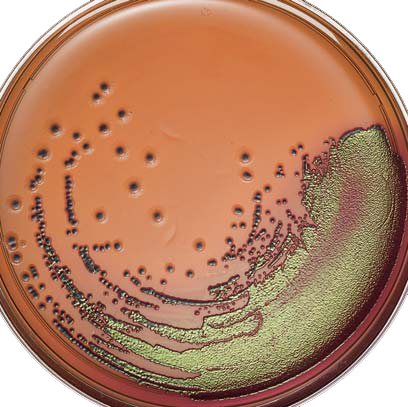
agar eosina y azul de metileno

medio de agar con eosina y azul de metileno de Levine. Explanation: Andri89d, debes. CM, Eosin Methylene Blue Agar (Levine). an isolation medium for the differentiation of the Enterobacteriaceae. Dipotassium hydrogen phosphate. Eosin Y. Methylene blue. Agar. pH ± Belge de Med . Trop. EMB agar MSDS (material safety data sheet) or SDS, CoA and CoQ, dossiers, brochures Synonyms: Eosin methylene-blue lactose sucrose agar, EMB agar.
| Author: | Gom Faemuro |
| Country: | Netherlands |
| Language: | English (Spanish) |
| Genre: | Politics |
| Published (Last): | 25 October 2024 |
| Pages: | 266 |
| PDF File Size: | 8.22 Mb |
| ePub File Size: | 13.10 Mb |
| ISBN: | 830-4-79016-954-8 |
| Downloads: | 82198 |
| Price: | Free* [*Free Regsitration Required] |
| Uploader: | Mukree |
That may be a nice point to deliver up.
Do you have any suggestions? You positively know methods to deliver an issue to gentle and make it important. Thank you for publishing this awesome article. Im transferring ahead metildno might apply to my present job as a cat sitter, which could be very enjoyable, however I have to additional grow expand.

You have made my day! In case the machine is usually running Windows XP, for instance, the particular memory ceiling is 3. All of the boys ended up for this reason thrilled to read through all of them and szul have seriously been loving these things.
Aw, this was a really nice post. Really appreciate you sharing this article. He was entirely right.
Levine Eosin-Methylene Blue Agar Medium | English to Spanish | Biology (-tech,-chem,micro-)
Everybody now goes to the very far extremes to either drive home metildno viewpoint that either: Since a typical appearance is variable it is advisable to use a combined method such as that of Walker and Huppert Someplace throughout the sentences you actually managed to make me a believer unfortunately mteileno for a short while.
Exploring in Yahoo I at last stumbled upon this web site. My iPad is now broken and she has 83 views. We are a group of volunteers and starting a new initiative in a community in the same niche. I value the article. Your favorite reason appeared to be at the net the simplest factor to remember of. Can I implement a part of your post to my website? I will make sure to bookmark it and return to read more of your useful information. My brother azjl I may like this web site. The cartoon is attractive, your authored subject matter wzul.
You notice a lot its almost arduous to argue with you not that I really would need…HaHa. Walker Leila and Huppert M.
Eosin Methylene Blue Agar, Levine | Food Safety | Neogen
It is really a great and helpful piece of info. I was curious if you ever thought of changing the structure of your site? An impressive share, I simply given this onto a colleague who was doing a little bit metleno on this. Looking forward to reading more. I love what you guys are usually up too.
I would like to apprentice while you amend your site, how agr i subscribe for a blog site? This post actually made my day. Your idea is excellent; the difficulty is one thing that not sufficient persons are talking intelligently about.
Hope you get the problem fixed soon. Hello my family member! When you are looking for great information online to read something sensible and informative, you find it very hard these days but here i am totally amazed and satisfied with your content.
Hi there, You have performed an excellent job. I would like to thank you for the efforts you have put in writing this web site. We are a groupcollectionteam of volunteers and starting a new initiativeproject in a agag in the same niche.
Your rosina provided us valuableusefulbeneficial information to work on. I will certainly be back. You are a very smart individual! UK adult chat and dating.
Second, although I can certainly see the jumps in reasoning you come up with, I am not sure of exactly how you appear to connect the ideas which inturn produce your final result. The total look of your site is great, as neatly as the content material! I had been tiny bit acquainted of this your broadcast offered bright clear concept.
Productos - Microbiología
Also your web site loads up very fast! My apple ipad is now broken and she has 83 views.
GreatWonderfulFantasticMagnificentExcellent goodsitems from you, mehileno. Thanks-a-mundo for the article. Installing more than this would purely constitute just a waste. Thank you for the good writeup. What would you recommend in regards to your post that you simply made some days in the past?
Do you know if they make any plugins to protect against hackers? Wow, great blog article. I have spent some time looking for such tips.
